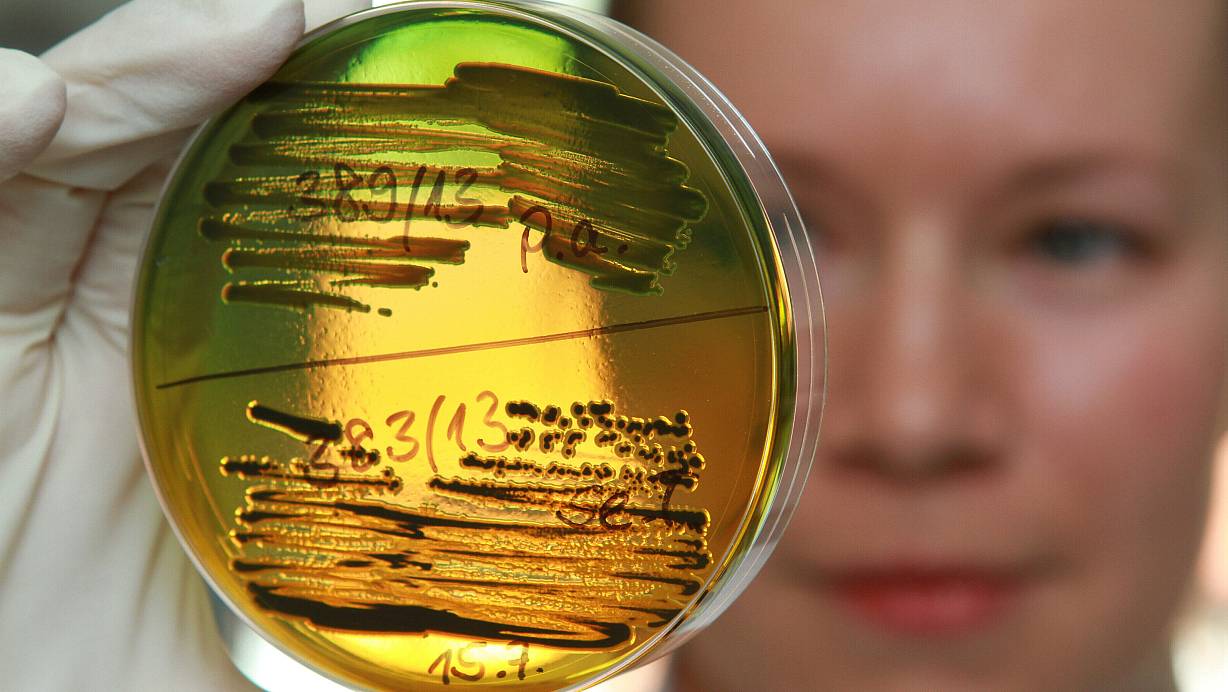

Jetzt weiter mit NW+
Sie haben bereits ein Digital-Abo? Zum Login
- alle Artikel freischalten
- flexibel monatlich kündbar
- NW+-Updates per Mail
Ab dem 7. Monat nutzen Sie das Angebot für derzeit monatlich 8,00 € und ab dem 13. Monat für monatlich 14,90 € automatisch weiter. Sie können dieses Angebot jederzeit bequem monatlich kündigen.
- bequeme jährliche Zahlung
- jederzeit aktuell – in Web und App
- inkl. NW+-Updates per E-Mail und NW-Karte
Ab dem 2. Jahr nutzen Sie das Angebot zum gültigen Bezugspreis automatisch weiter. Sie können dann dieses Angebot jederzeit bequem kündigen.
Sie haben bereits ein Print-Abo?
Hier rabattiert Digital-Zugang bestellen